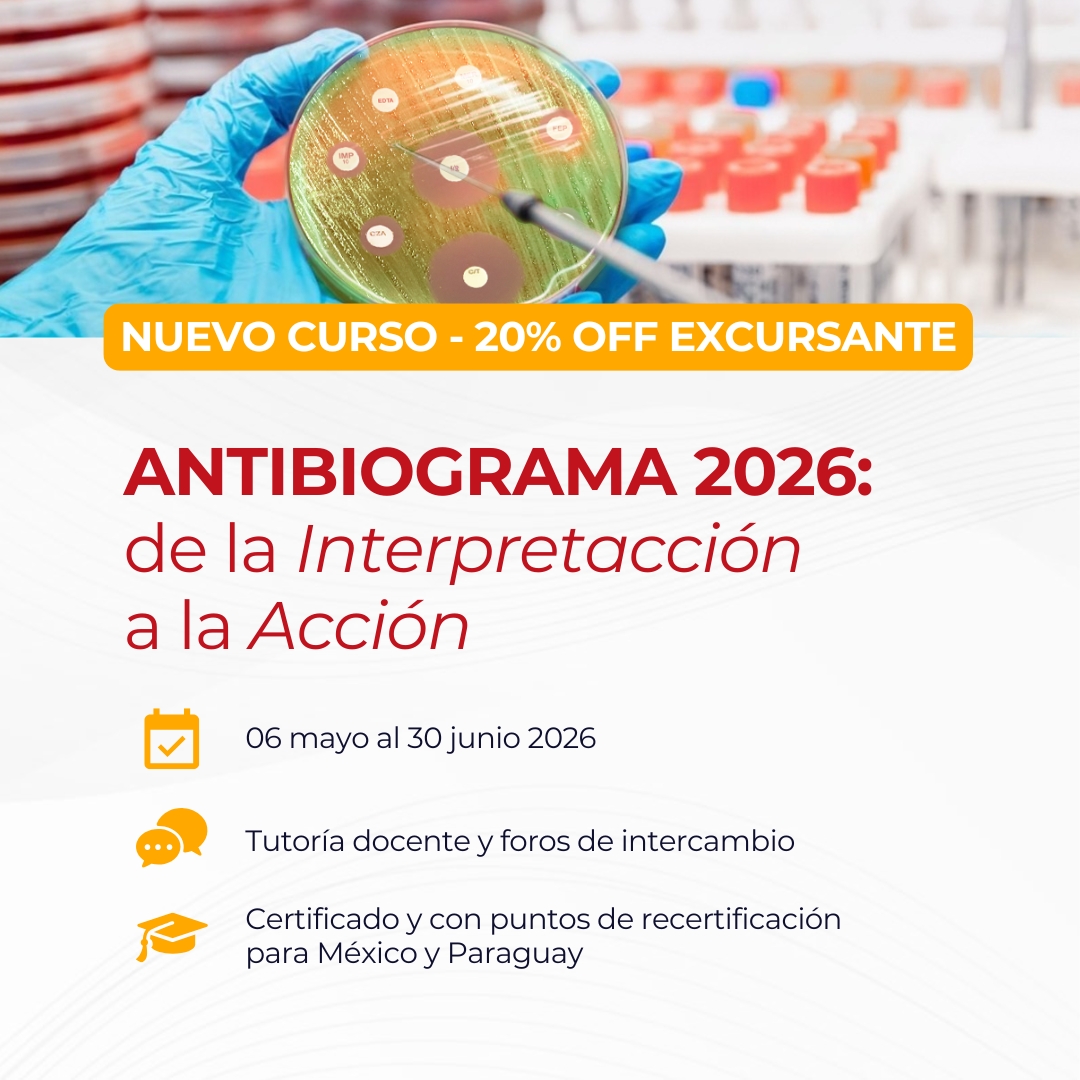

Extendemos hasta el 9/12/25, inclusive, el plazo para autogestionar el Certificado
Introducción
El curso Multirresistencia 2025: Abordaje integral de las infecciones en la era de microorganismos difíciles de tratar es organizado por la Red de Educación Médica Continua en Iberoamérica (redEMC), en conjunto con la Asociación Mexicana de Infectología y Microbiología Clínica (AMIMC) y la Sociedad Brasilera de Infectología (SBI), con el apoyo de la Asociación Panamericana de Infectología (API).
Patrocinio Científico: de la Sociedad Española de Enfermedades Infecciosas y Microbiología Clínica (SEIMC) y la Sociedad Portuguesa de Enfermedades Infecciosas y Microbiología Clínica (SPDIMC).
Dirigido a: infectólogos, internistas, intensivistas, microbiólogos, bioquímicos, técnicos del laboratorio, farmacéuticos, enfermeros en control de infecciones, y otros profesionales de la Salud interesados..
Dirección académica a cargo de la Dr. Juan Pablo Horcajada (SEIMC-España), Dr. Javier Farina (SADI/SATI-Argentina), Dra. Patricia Rodríguez Zulueta (AMIMC-México)y el Dr. Alberto Chebabo (SBI-Brasil).
Objetivo del curso:
- Fortalecer las competencias clínicas y microbiológicas de los profesionales de la salud para el diagnóstico oportuno y el abordaje inicial de infecciones causadas por microorganismos multirresistentes (MOR), incorporando herramientas como scores clínicos, estudios de vigilancia, nuevas metodologías diagnósticas y el uso optimizado de antimicrobianos.
- Brindar criterios actualizados para la selección y optimización del tratamiento antimicrobiano, desde la terapia empírica hasta el tratamiento dirigido, integrando factores como el foco infeccioso, la epidemiología local, los perfiles de resistencia y los principios farmacocinéticos/farmacodinámicos (Pk/Pd).
- Actualizar conocimientos sobre el manejo específico de infecciones por patógenos multirresistentes clave, como Staphylococcus aureus MR, enterococos resistentes a vancomicina , enterobacterias productoras de carbapenemasas, bacilos gram negativos no fermentadores multirresistentes y Clostridioides difficile, así como infecciones fúngicas por Candida spp.
- Promover la implementación efectiva de Programas de Optimización de Antimicrobianos (PROA) y de Diagnóstico Microbiológico (PRODIM) en los distintos niveles de atención, derribando mitos sobre el tratamiento antibiótico y fomentando una toma de decisiones basada en evidencia.
Duración: 1º de octubre al 25 de noviembre de 2025
Carga horaria: 30 horas de estudio.
Dedicación esperada: mínimo 4 horas semanales, en horario libre administrado por el participante. Descargar Programa
¡Éxitos!
Modalidad
El curso se desarrollará online del 1ro de octubre al 25 de noviembre2024, a través de la plataforma redEMC. Ofrece acceso en español a materiales y actividades prácticas específicamente diseñados para esta propuesta de educación continua.
El progreso académico será semanal, con la apertura de un nuevo módulo cada miércoles a partir del 9 de octubre. Una vez habilitado, los materiales de cada módulo permanecerán accesible on-demand.
La flexibilidad de la actividad online permite a los participantes acceder al campus virtual desde cualquier lugar y en cualquier momento.
En la sección "Módulos", que encontrará al final de esta página, podrá ingresar a cada uno de los módulos académicos.
Equipo Docente
(Director Académico) Dr. Juan Pablo Horcajada. Jefe de Servicios de Enfermedades Infecciosas, Hospital Mar. Coordinador del Grupo de Investigación en Patología Infecciosa y Antimicrobianos (IPAR). Barcelona - España.
(Director Académico) Dr. Javier Farina. Médico especialista en infectología y medicina interna. Miembro de SADI. Ex director del comité de infectología crítica de SATI. Jefe de Infectología del Hospital de alta complejidad Cuenca Alta y Hospital Mariano y Luciano de la Vega, Buenos Aires - Argentina.
(Coordinador Científico) Dra. Patricia Rodríguez Zulueta. Jefa de la División Infectología Adultos, Hospital “Dr. Manuel GEA González”, Ciudad de México. Profesora de Infectología de pre y post grado en la Universidad Nacional Autónoma de México (UNAM) y la Universidad La Salle. México
(Coordinador Científico) Dr. Alberto Chebabo. Director médico del Hospital Universitario «Clementino Fraga Filho», UFRJ. Presidente de la Sociedad Brasileña de Infectología. Brasil
Dr. Rafael Cantón, PhD. Jefe del Departamento de Microbiología. Hospital Universitario Ramón y Cajal. Profesor Asociado en la Universidad Complutense, Madrid. Past Presidente de SEIMC. Past Presidente de EUCAST y Miembro del Consejo Asesor de la Joint Programming Initative Antimicrobial Resistance (JPIAMR). ESCMID Fellow. España.
Dr. Ricardo Ferrer. Jefe del Servicio de Medicina Intensiva, Hospital Vall d'Hebron Barcelona, España.
Dra. Silvia Gómez-Zorrilla, PhD. Médico adjunto del Servicio de Enfermedades Infeciosas del Hospital del Mar. Hospital del Mar Research Institute. Profesora asociada de la Universidad Pompeu Fabra. CIBERINFEC. Barcelona, España.
Dra. Lorena López Cerero. Profesora Titular de Microbiología, Universidad de Sevilla, Andalucía. Facultativo Especialista en Microbiología (UGC Microbiología, Enfermedades Infecciosas y Medicina Preventiva), Hospital Universitario Virgen Macarena, Sevilla - España.
Dra. Patricia Ruiz Garbajosa (España) Servicio de Microbiología, Hospital Universitario Ramón y Cajal & Instituto Ramón y Cajal de Investigación Sanitaria (IRYCIS). Enfermedades Infecciosas (CIBERINFEC), Instituto de Salud Carlos III, Madrid, España.
Dra. Mila Montero. Jefa de Sección de Infección Nosocomial, Servicio de Enfermedades Infecciosas, Hospital del Mar Infectóloga. Profesora asociada de la Universitat Pompeu Fabra, Barcelona, España.
Dr. Adrian Camacho Ortiz, PhD. Especialidad en Infectología y Medicina Interna, por la Universidad Autónoma de Nuevo León y la Universidad Nacional Autónoma de México. Doctorado en Medicina en la Universidad Autónoma de Nuevo León. Jefe de Departamento en el Hospital Universitario “Dr. José Eleuterio González”, Monterrey, Nuevo León. México
Dra. Lorena Sandra Díaz Ortiz, PhD. Bacterióloga, PhD. en Ciencias Biológicas. Profesora Asociada, Investigadora del grupo de Genómica y Resistencia Microbiana (GeRM) de la Facultad de Medicina, Universidad del Desarrollo - Clínica Alemana. Chile
Dr. Germán Esparza. Bacteriólogo y microbiólogo clínico. Profesor de antimicrobianos en los programas de pre-grado y post grado en microbiología médica, Pontificia Universidad Javeriana, Bogotá. Profesor de la residencia en enfermedades infecciosas de la Universidad del Rosario. Miembro del panel de expertos en microbiología de la CLSI de Estados Unidos. Coordinador del comité de microbiología clínica de la Asociación Panamericana de Infectología. Colombia.
Dra. María Virginia Villegas. Infectóloga, Magister en Microbiología y Fellow en Resistencia Bacteriana. Directora del laboratorio de Resistencia Antimicrobiana y Epidemiología Hospitalaria (RAEH) y Profesora Adjunta de la Universidad El Bosque. Colombia
Dr. Arnaldo Lopes Colombo. Profesor Titular de Disciplina de Enfermedades Infecciosas, Escuela Paulista de Medicina - Universidad Federal, Brasil.
Dr. Claudio Querido Fortes. Profesor Asociado de la Facultad de Medicina de la Universidad Federal de Río de Janeiro y Profesor Titular de la Facultad de Medicina de la Universidad Estácio de Sá. Brasil
Dra. Wanda Cornistein. Coordinadora del PROA y Jefa del Servicio de Prevención y Control de infecciones del Hospital Universitario Austral, acreditado por Joint Commission International. Embajadora en Control de Infecciones de la Society for Healthcare Epidemiology of America SHEA 2021. Especialista en Docencia Universitaria (UBA) y Directora de la Maestría en Prevención y Control de Infecciones de la Universidad Austral. Miembro de la Comisión Directiva y Comisión de Infecciones Asociadas a los Cuidados de la Salud (IACS) de la Sociedad de Infectología de Argentina, SADI. Miembro del Comité de Infectología Crítica de la Sociedad Argentina de Terapia Intensiva (SATI).
Dra. Gabriela Zambrano. Profesora de Enfermedades Infecciosas e Inmunología Clínica de la Universidad Central de Ecuador. Profesora de Clínica Médica de la Universidad Internacional de Ecuador. Profesora de posgrado de la Pontificia Universidad Católica de Ecuador. y Miembro del Comité Covid-19 de la Asociación Panamericana de Infectología.
Dra. Nancy Sandoval. Profesora titular de Pregrado de Medicina Interna de Universidad Rafael Landívar. Máster Internacional en Enfermedades Parasitarias Tropicales por Universidad de Valencia, España. Maestría en Enfermedades Infecciosas del Hospital del Mar, Universidad Autónoma de Barcelona, España. Past president de la Asociación Guatemalteca de Enfermedades Infecciosas (AGEI) y de la Asociación Centroamericana y del Caribe de Infectología (ACENCAI).
Auspiciantes Académicos
Premiamos la participación en los Foros de intercambio
Sabemos que compartir conocimientos y experiencias entre colegas enriquece el aprendizaje de todos, empezando por los que deciden compartir lo que saben, por eso queremos destacar a quienes más se involucren respondiendo a las preguntas de sus colegas.
¡Sus aportes no pasarán desapercibidos! Al finalizar el curso, premiaremos a los 10 cursantes que hayan mostrado mayor participación y compromiso en los foros, respondiendo las dudas de los demás participantes. Estos cursantes recibirán como reconocimiento:
- Certificado especial como Colaborador Académico.
- Reconocimiento del aumento de las horas de dedicación, acreditándose un total de 40hs.
- Una beca total al curso de su elección en modalidad flexible.
A medida que participen, los comentarios con más “me gusta” serán reconocidos como recomendados, y los nombres de los cursantes más activos aparecerán en un ranking especial.
¡Esperamos con entusiasmo aprender entre todos!
Equipo Docente
Requisitos de aprobación
Actividad obligatoria M1: Red Profesional
Actividad obligatoria M2: Simulación Clínica
Actividad obligatoria M3: Simulación Clínica
Actividad obligatoria M4: Simulación Clínica
Actividad obligatoria M5: Simulación Clínica
Actividad obligatoria M6: Simulación Clínica
Actividad obligatoria M7: Simulación Clínica
Actividad obligatoria M8: Compromiso de Cambio.
Quienes completen estos requisitos dentro del plazo estipulado, obtendrán un certificado de aprobación indicando la carga horaria, emitido por la organización del curso.
Quienes completen algunos requisitos, pero no todos, obtendrán una constancia de participación emitida por la organización del curso.
Una vez que complete los requisitos de aprobación establecidos e identificados como tal en campus, podrá solicitar durante las "Actividades finales" su certificación en el apartado 'Módulos' que se mostrará en la sección derecha de cada módulo, siempre y cuando esté habilitado según su progreso educativo.
Por favor revise -y modifique en caso de ser necesario- el nombre que figura en su perfil de usuario, ya que el mismo será utilizado para la confección de los certificados. Una vez solicitada su certificación, se le enviará un correo electrónico con el enlace de descarga.
ATENCIÓN: Sólo tendrá dos intentos para corregir el nombre y apellido de su certificado. Una vez que se haya solicitado, podrá descargarlo tantas veces como sea necesario desde su correo electrónico o desde su perfil en este campus virtual.
Reglas básicas de comportamiento en la red
1.Nunca olvide que la persona que lee el mensaje es humana, con sentimientos que pueden ser lastimados.
2.Adopte en línea los mismos estándares de comportamiento que usted sigue en la vida real.
3.Escribir todo en mayúsculas se considera como gritar y además, dificulta la lectura.
4. Respete el tiempo y ancho de banda de las otras personas.
5.Muestre el lado bueno de su persona mientras se mantenga en línea.
6.Comparta su conocimiento con la comunidad.
7.Ayude a mantener los debates en un ambiente sano y educativo.
8.Respete a las terceras personas, hacer un grupo contra una persona está mal.
9.No abuse de su poder.
10.Perdone los errores ajenos.

Comentarios generales del curso "Multirresistencia 2025: Abordaje integral de las infecciones en la era de microorganismos difíciles de tratar"